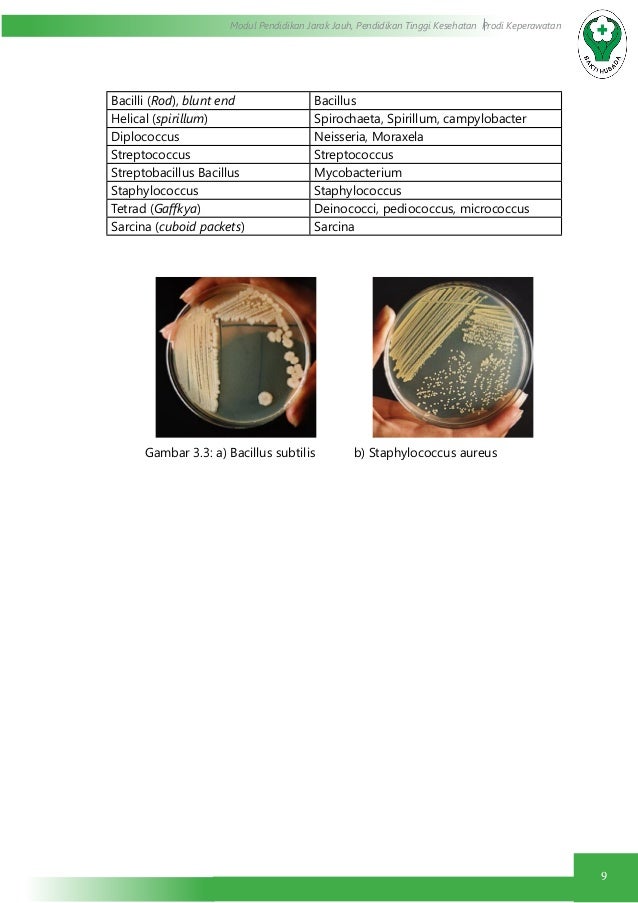

Top 34+ Gambar Jamur Berwarna
Januari 01, 2021
Gambar jamur kancing, Gambar Jamur Animasi, Jamur berwarna orange, Macam macam jamur dan Gambarnya, Gambar jamur merang, 100 nama latin jamur dan Gambarnya, Gambar jamur kayu, Jamur yang tumbuh di kayu mati, Jenis jamur kayu, Gambar jamur tiram, 100 jenis jamur,
Top 34+ Gambar Jamur Berwarna - Mengatur wallpaper atau gambar latar belakang di perangkat smartphone, iPhone atau komputer merupakan hal yang berharga. Berburu wallpaper ialah sebuah kegiatan yang pastinya sering dilakukan tidak terkecuali mencari gambar berwarna. Jika kamu melihat gambar jamur berwarna ini pun merasa jadi ingin cepat-cepat mengganti wallpaper desktop di PC ataupun laptop milikmu.
Disini kami telah mengumpulkan berbagai macam gambar berwarna yang tentunya menarik untuk disimak. Berikut kami sajikan Top 34+ gambar jamur berwarna.

Tani Jamur Desa Tuwed MELAYA Jenis jenis Jamur Tiram . Sumber Gambar : tanijamurtuwed.blogspot.com
15 Jenis Jamur yang Bisa Dimakan dan Bernutrisi
8 13 2021 12 Jamur Portobello Sumber Gambar Inspired Taste Jamur yang berwarna kecoklatan ini termasuk dalam jenis jamur besar Dengan lingkar kelopak sampai 13 meter jamur portobello cocok untuk dikonsumsi dengan cara dipanggang ditumis ataupun dicincang menjadi campuran hamburger
Olivia Cooks in Holland MIE AYAM JAMUR MUSHROOM CHICKEN . Sumber Gambar : oliviacooksinholland.blogspot.com
10 Jenis Jamur Paling Beracun di Dunia Tentik
10 8 2021 10 Amanita Jamur amanita tumbuh secara liar di antara daun daun yang jatuh ke tanah Jamur ini bisa ditemukan di hutan ataupun pekarangan rumah Ada beberapa jenis jamur amanita yaitu amanita spisa dengan tudung payung berwarna coklat tua dan bintik putih amanita muscaria dengan tudung payung berwarna merah dan bintik putih amanita umbrina dengan tubuh menggulung berwarna

Cara Sukses Untuk Mulai Membudidayakan Jamur Tiram seruni id . Sumber Gambar : seruni.id
7 Jamur Jepang yang Paling Terkenal di Dunia Apa Saja
10 17 2021 Jamur unik tersebut memiliki tudung berwarna kuning yang sekilas mirip dengan jeruk Lapisan Nameko amatlah empuk seperti agar agar Bagi yang mengonsumsinya akan mendapatkan manfaat berupa kesehatan tulang yang baik karena kandungan Kalsium dalam satu porsi Nameko setara dengan segelas susu bukan iklan permen lho ya ini

7 Jenis Jamur Beracun Bisa Bikin Gila Sampai Menyebabkan . Sumber Gambar : www.idntimes.com
Klasifikasi Jamur Zygomycota Ascomycota Basidiomycota
11 10 2021 Morchella esculenta jamur yang memiliki tubuh buah mengandung banyak air dan enak dimakan Gambar 4 Jamur ini sering ditemukan di bawah pohon buah buahan Claviceps purpurea merupakan jamur Ascomycota berwarna ungu yang biasa disebut ergot bersifat parasit pada gandum hitam rye Bila jamur ini ikut tergiling bersama gandum dan tercampur

laporan praktikum mikrobiologi morfologi cendawan fungi . Sumber Gambar : www.idbiodiversitas.xyz
Jamur Tiram Merah Berbisnis Jamur
Ada beberapa jenis jamur tiram yang dapat dibudidayakan dan salah satunya yaitu jamur tiram merah Jamur tiram merah plerotus fisbelatus juga mampu tumbuh secara saprofit pada berbagai batang kayu Jamur tiram merah memiliki ciri fisik sebagai berikut Badan buah dengan tudung pileus berwarna merah merah muda merah pucat sampai kekuningan

Macam Macam Klasifikasi Makhluk Hidup Gambar Dan . Sumber Gambar : www.moondoggiesmusic.com
Bahaya 6 Jamur Berwarna Gelap Ini Beracun dan Mematikan
6 Jamur Berwarna Gelap Ini Beracun dan Mematikan Mungkin jamur dengan nama latin amanita phalloides ini paling mematikan dari semua jamur Death Cap ditemukan di seluruh Eropa dan sangat mirip jamur jerami yang dapat dimakan Racun amatoxins pada jamur ini dapat bertahan saat dimasak Apabila dikonsumsi cepat merusak sel sel di seluruh tubuh

Cara Memulai Bisnis Sup Jamur Kekinian Enak Bikin Nagih . Sumber Gambar : bisnisukm.com

JAWA RANTAU NGUDARASA OPT UTAMA PADA TANAMAN JAGUNG DAN . Sumber Gambar : jawarantau.blogspot.com

Kurap Gejala penyebab dan mengobati Alodokter . Sumber Gambar : www.alodokter.com

Tanaman Unik Menyerupai Bagian Tubuh Manusia Berita Aneh . Sumber Gambar : www.anehdidunia.com

Bunga Rampai Senja LAPORAN KULIAH KERJA LAPANGAN STUDI . Sumber Gambar : tintasenjaaa.blogspot.com
Bunga Rampai Senja LAPORAN KULIAH KERJA LAPANGAN STUDI . Sumber Gambar : tintasenjaaa.blogspot.com
Mengintip Dapur Kerajaan dan Makanan Favorit Ratu Inggris . Sumber Gambar : www.cnnindonesia.com

BIOLOGI I LAPORAN PRAKTIKUM MIKROBIOLOGI UMUM TEKNIK . Sumber Gambar : biologi-i.blogspot.com

Gambar Bunga Teratai Yang Cantik Kumpulan Gambar . Sumber Gambar : gambarku3.blogspot.com

Cara Memahami Pengertian Tanda Gejala Tipe Gejala dan . Sumber Gambar : mukegile08.wordpress.com

Gambar Berbagai Macam Sayur sayuran . Sumber Gambar : satujam.com

Fashion Busana Adat Sejarah Dan Perkembangan Kebaya Page 2 . Sumber Gambar : nithadyatmikadewi.wordpress.com
MATERI BIOLOGI SISTEM REPRODUKSI MANUSIA . Sumber Gambar : sisirahmawati09.blogspot.com
Pewarnaan Bakteri . Sumber Gambar : www.slideshare.net